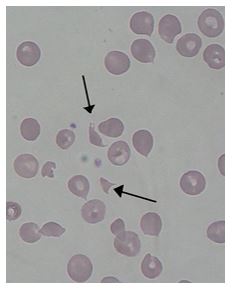

A 50 year old male patient receiving chemotherapy for treatment of gastric cancer presented to ER. Labs reported:
WBC = 5.4 x 103/μL
Hgb = 8.9 g/dL
PLT (impedance) = 26 x 103/μL
PLT-F (fluorescent) = 9 x 103/μL
IPF = 21%
The hemoglobin was consistent with the patient history. Flags on the original impedance platelet count included thrombocytopenia, platelet clumps and platelet abnormal distribution. The sample was checked for clots, with no clots found. A fluorescent platelet count (PLT-F) was reflexed and the critical platelet count was called to the ER physician. The high immature platelet fraction (IPF%) indicates increased platelet production. Despite the increased production, the patient still had a severe thrombocytopenia. This would suggest thrombocytopenia caused by platelet destruction or consumption. Examination of the blood smear showed the presence of moderate numbers of schistocytes.
Additional labs were ordered. BUN and Creatinine were slightly elevated. PTINR and APTT were within normal range. LDH was markedly increased. The physician was able to use this information, along with the clinical presentation and history, to diagnose Thrombotic Thrombocytopenic Purpura (TTP). Plasma exchanges were initiated. The patient expired 3 days later.
The difference between the impedance platelet count and the fluorescent platelet count in this patient is actually related to the presence of schistocytes. With thrombocytopenia, platelet counts can be less reliable than with normal counts. Automated platelet counts were originally performed by impedance methods, then better accuracy and precision was obtained with optical platelet counts. Physicians rely on precision with very low platelet counts to make informed decisions about treatment. The problem with the impedance counts at the low end is that RBC fragments, schistocytes and microcytic RBCs can be counted as platelets, giving a falsely high count, as we see in this case. On the other hand, measuring platelets by size (optical) can miss large platelets leading to a falsely low count. The PLT-F is more reliable because it uses a platelet specific dye which eliminates these interferences. The fluorescent dye labels the RNA. Forward scatter is used to determine size while fluorescence is used to measure RNA content. With gating set based on cell volume and RNA content, the PLT-F can be measured. When there is an abnormal scattergram or a low platelet count, the PLT-F is reflexed and the IPF% is also reported.
The Immature platelet fraction (IPF) can also be used to help understand the etiology and aid in diagnosis. Historically, the MPV has been used as an indirect marker for platelet production. However, an inherent problem with the MPV is that, similarly to the impedance platelet count, this count can be unreliable because any RBC fragments or particles may interfere with the measurement. Reticulated or immature platelets are the youngest platelets, within 24 hours of being released from the bone marrow. Measurement of these is a concept that first emerged in the late 1960s, before automated hematology analyzers performed platelet counts. Thus, the original method was staining with new methylene blue and manually counting, much like a manual reticulocyte count. These manual methods tend to be tedious and imprecise. In the last 20 yeas we have developed flow cytometry methods for performing a reticulated platelet count. Reticulocytes are stained with Thiazole Orange and passed through a flow cytometer. Unfortunately, there is no standardization for the procedure as there are variations in dye concertation, timing and gate settings. As well, this method is also time consuming, labor intensive, costly, and requires highly trained technologists to perform.
Newer flow cytometry methods to count these youngest platelets are available on Sysmex and Abbott CELL-DYN analyzers. The IPF (Sysmex) or RetPLT(Abbott) can be performed along with the routine CBC with no additional sample or time required. Knowing the reticulated or immature platelet fraction can help physicians to differentiate pathogenesis. A decreased percent of newly formed platelets may indicate that thrombocytopenia is caused by deficient platelet production, as seen in bone marrow failure. Increased circulating immature platelets with a low platelet count may suggest that the bone marrow is making adequate platelets and the thrombocytopenia is caused by platelet destruction or consumption. Treatment for these scenarios is different, and the physician must determine the etiology in order to determine treatment
Thrombotic thrombocytopenic purpura (TTP) is a microangiopathic hemolytic anemia with thrombocytopenia and organ failure caused by microvascular thrombosis. Platelets clump in the small blood vessels and cause the low platelet count. The hemolytic anemia causes schistocytes which can be seen on the peripheral blood smear. In this case, the low platelet count and high IPF, schistocytes on the smear and the patient presentation were all important factors that led to a speedy diagnosis and start of therapy.
Plasma exchange is the treatment of choice for TTP. With the advent of therapeutic plasma exchange, mortality from TTP has decreased from about 90% to 10-20%. In patients who have relapses or become refractory, vincristine has been used successfully as an adjunct to plasma exchange.4 The exact etiology of TTP is unknown. It can be secondary TTP, often triggered by chemotherapy drugs, or can be sporadic. Sporadic, or idiopathic, TTP is now thought to be associated with an acquired autoimmune deficiency of a plasma metalloprotease named ADAMTS13. The ADAMTS13 gene controls this enzyme, which is involved in blood clotting. In acquired TTP, the ADAMTS13 gene isn’t faulty. Instead, the body makes antibodies that block the activity of the ADAMTS13 enzyme. In these cases, a lack of activity in the ADAMTS13 leads to TTP. Almost all cases of recurrent TTP have severe ADAMTS13 deficiency. These patients benefit from immunosuppressive therapy with vincristine along with plasma exchange.
However, despite the decreased mortality seen with plasma exchange, patients with cancer, infections, transplant patients, or those receiving certain drug therapy have a much worse prognosis.4 In this case study, this was this patient’s first episode of TTP and he was undergoing chemotherapy for gastric cancer. The patient’s unfortunate outcome is most likely linked to this finding.
References
- Arshi Naz et al. Importance of Immature platelet Fraction as a predictor of immune thrombocytopenic purpura. Pak J Med Sci 2016 Vol 32 No 3:575-579
- Johannes J. M. L. Hoffmann, Nicole M. A. van den Broek, and Joyce Curvers (2013) Reference Intervals of Reticulated Platelets and Other Platelet Parameters and Their Associations. Archives of Pathology & Laboratory Medicine: November 2013, Vol. 137, No. 11, pp. 1635-1640.
- M Meintker, Lisa & Haimerl, Maria & Ringwald, Juergen & Krause, Stefan. (2013). Measurement of immature platelets with Abbott CD-Sapphire and Sysmex XE-5000 in haematology and oncology patients.
- J. Evan Sadler, Joel L. Moake, Toshiyuki Miyata, James N. George Clinical chemistry and laboratory medicine : CCLM / FESCC. 51. 1-7. 10.1515/cclm-2013-0252.; Recent Advances in Thrombotic Thrombocytopenic Purpura. Hematology Am Soc Hematol Educ Program 2004; 2004 (1): 407–423. doi: https://doi.org/10.1182/asheducation-2004.1.407
- Sysmex White Paper. The role of the Immature Platelet Fraction(IPF) in the differential diagnosis of thrombocytopenia. www.sysmex.com/us

-Becky Socha, MS, MLS(ASCP)CM BB CM graduated from Merrimack College in N. Andover, Massachusetts with a BS in Medical Technology and completed her MS in Clinical Laboratory Sciences at the University of Massachusetts, Lowell. She has worked as a Medical Technologist for over 30 years. She’s worked in all areas of the clinical laboratory, but has a special interest in Hematology and Blood Banking. When she’s not busy being a mad scientist, she can be found outside riding her bicycle.